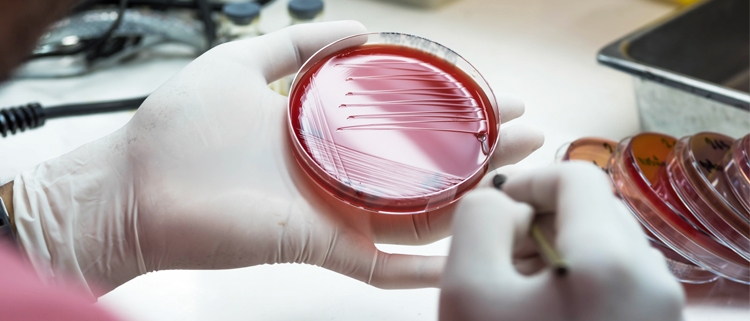
Meningitis

Els nous ceps virulents de la meningitis
Cada any es registren al voltant de 1.000 casos de meningitis segons dades de la Societat Espanyola de Neurologia. Un percentatge alt són d’origen víric, mentre que la resta són causats per bacteris i són els més perillosos. En els darrers anys han arribat a Espanya ceps molt virulents d’aquesta malaltia que pot ser mortal en els nens i adolescents si no es diagnostica a temps.
Què és la meningitis?
La meningitis és una malaltia que es caracteritza per la inflamació aguda de les membranes que envolten el sistema nerviós central (cervell i medul·la espinal). És difícil de detectar perquè els seus símptomes s’assemblen molt a un quadre clínic de grip:
- Mal de cap intens i continu.
- Febre alta.
- Vòmits
- Taques a la pell.
- Rigidesa del coll.
Noves vacunes per fer front a l’increment de ceps virulents de la meningitis
L’any passat es va detectar un increment dels ceps més virulents de la meningitis, cosa que va provocar que la incidència de la malaltia arribés a índexs d’alerta. La taxa d’afectació es va situar en l’1,45 per cada 100.000 habitants. Aquesta xifra no hauria de superar l’1,25. A més, els professionals adverteixen que cada vegada amb més freqüència la malaltia que es diagnostica pertany als ceps més perillosos.
Per això, des del comitè assessor de vacunes de l’Associació Espanyola de Pediatria han demanat que s’inclogui dins dels calendaris de vacunació de les diferents Comunitats Autònomes una protecció contra el meningococ C i concretament contra els subtipus A, W i Y.
Factors de risc que faciliten el contagi per meningitis
- No vacunar els nens.
- Edat. La majoria dels casos es donen en menors de vint anys.
- Embaràs. Aquesta etapa de la vida incrementa el risc de listeriosi, una infecció provocada per un bacteri que també pot fer que es desenvolupi meningitis.
- Sistema immunitari dèbil. La diabetis, la SIDA i altres malalties poden incrementar el risc de contraure meningitis.

Deixar un comentari
Vols comentar?No dubtis a contribuir!